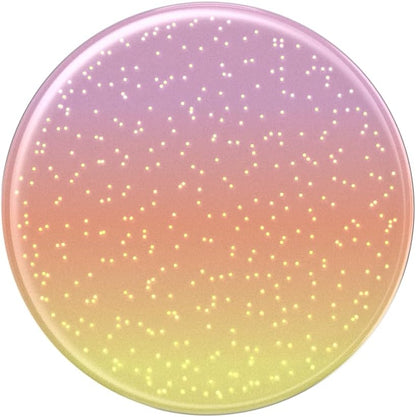
PopSockets Phone Grip with Expanding Kickstand, Adhesive Grip - Aura Sunrise

1
/
of
6
PopSockets
PopSockets Phone Grip with Expanding Kickstand, Adhesive Grip - Aura Sunrise
PopSockets Phone Grip with Expanding Kickstand, Adhesive Grip - Aura Sunrise
Regular price
$16.88 USD
Regular price
Sale price
$16.88 USD
Shipping calculated at checkout.
Quantity
Couldn't load pickup availability
Overview
- Brand : PopSockets
- Color : Aura Sunrise
- Special Feature : Expanding Kickstand
- Material : Plastic
- Grip Type : Pop Socket
About this item
- Our durable PopSockets for iPhone, Samsung and any other devices, we call a “PopGrip” is anti-drop, allows for one-handed use of your device, and the ability to prop up your phone wherever you go
- A little life-changer people like to call: a cell phone holder, phone gripper for back of phone, phone holder for hand, or whichever you name you decide
- PopSockets are compatible with all Popsocket phone accessories including wallets, cases, mounts, slides and non-Popsocket cases for phones. PopSockets stick best to smooth hard plastic cases (may not stick to silicone, soft, or waterproof cases).
- Stick on with the adhesive and reposition as needed. PopSockets stick best to smooth hard plastic cases (may not stick to silicone, soft, or waterproof cases)
- Change up your PopGrip style without replacing the whole grip and swap out the top for one of our PopTops. Just press flat, turn 90 degrees until you hear a click and swap
Share